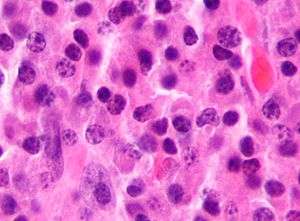

Multiple myeloma
| Multiple myeloma | |
|---|---|
| Plasma cell myeloma, myelomatosis, or Kahler's disease | |
|
| |
| Classification and external resources | |
| Specialty | Hematology and oncology |
| ICD-10 | C90.0 |
| ICD-9-CM | 203.0 |
| ICD-O | M9732/3 |
| OMIM | 254500 |
| DiseasesDB | 8628 |
| MedlinePlus | 000583 |
| eMedicine | med/1521 |
| Patient UK | Multiple myeloma |
| MeSH | D009101 |
Multiple myeloma, also known as plasma cell myeloma, is a cancer of plasma cells, a type of white blood cell normally responsible for producing antibodies.[1] Initially, often no symptoms are noticed. When advanced, bone pain, bleeding, frequent infections, and anemia may occur.[2] Complications may include amyloidosis.[3]
The cause is generally unknown.[4] Risk factors include drinking alcohol and obesity.[5] The underlying mechanism involves abnormal plasma cells producing abnormal antibodies which can cause kidney problems and overly thick blood. The plasma cells can also form a mass in the bone marrow or soft tissue. When only one mass is present, it is known as a plasmacytoma while more than one is known as multiple myeloma.[2] Multiple myeloma is diagnosed based on blood or urine tests finding abnormal antibodies, bone marrow biopsy finding cancerous plasma cells, and medical imaging finding bone lesions. Another common finding is high blood calcium levels.[1]
Multiple myeloma is considered treatable but generally incurable.[3] Remissions may be brought about with steroids, chemotherapy, thalidomide or lenalidomide, and stem cell transplant.[3] Bisphosphonates and radiation therapy are sometimes used to reduce pain from bone lesions.[1][3]
Multiple myeloma affected about 427,000 people in 2013 and resulted in 79,000 deaths.[6][7] In the United States it develops in 6.5 per 100,000 people per year and 0.7% of people are affected at some point in their life.[8] It usually occurs around the age of 61 and is more common in men than women.[1] Without treatment, typical survival is seven months. With current treatments, survival is usually 4–5 years.[3] This gives a five-year survival rate of about 49%.[8] The word myeloma is from the Greek myelo- meaning "marrow" and -oma meaning "tumor".[9]
Signs and symptoms
Because many organs can be affected by myeloma, the symptoms and signs vary greatly. A mnemonic sometimes used to remember some of the common symptoms of multiple myeloma is CRAB: C = Calcium (elevated), R = Renal failure, A = Anemia, B = Bone lesions.[10] Myeloma has many other possible symptoms, including opportunistic infections (e.g., pneumonia) and weight loss. CRAB symptoms and proliferation of monoclonal plasma cells in the bone marrow are part of the diagnostic criteria of multiple myeloma.
Bone pain

Bone pain affects almost 70% of patients and is the most common symptom.[11] Myeloma bone pain usually involves the spine and ribs, and worsens with activity. Persistent localized pain may indicate a pathological bone fracture. Involvement of the vertebrae may lead to spinal cord compression or kyphosis. Myeloma bone disease is due to the overexpression of receptor activator for nuclear factor κ B ligand (RANKL) by bone marrow stroma. RANKL activates osteoclasts, which resorb bone. The resultant bone lesions are lytic (cause breakdown) in nature and are best seen in plain radiographs, which may show "punched-out" resorptive lesions (including the "raindrop" appearance of the skull on radiography). The breakdown of bone also leads to release of calcium into the blood, leading to hypercalcemia and its associated symptoms.
Anemia
The anemia found in myeloma is usually normocytic and normochromic. It results from the replacement of normal bone marrow by infiltrating tumor cells and inhibition of normal red blood cell production (hematopoiesis) by cytokines.
Kidney failure
Kidney failure may develop both acutely and chronically.
The most common cause of kidney failure in multiple myeloma is due to proteins secreted by the malignant cells. Myeloma cells produce monoclonal proteins of varying types, most commonly immunoglobulins (antibodies) and free light chains, resulting in abnormally high levels of these proteins in the blood. Depending on the size of these proteins, they may be excreted through the kidneys. Kidneys can be damaged by the tubulopathic effects of proteins or light chains. Increased bone resorption leads to hypercalcemia and causes nephrocalcinosis, thereby contributing to the kidney failure. Amyloidosis is a distant third in the causation. Patients with amyloidosis have high levels of amyloid protein that can be excreted through the kidneys and cause damage to the kidneys and other organs.
Light chains produce myriad effects which can manifest as the Fanconi syndrome (type II renal tubular acidosis).
Other causes include hyperuricemia, recurrent infections (pyelonephritis), local infiltration of tumor cells, and drug induced.
Infection
The most common infections are pneumonias and pyelonephritis. Common pneumonia pathogens include S. pneumoniae, S. aureus, and K. pneumoniae, while common pathogens causing pyelonephritis include E. coli and other Gram-negative organisms. The greatest risk period for the occurrence of infection is in the initial few months after the start of chemotherapy.[12] The increased risk of infection is due to immune deficiency. Although the total immunoglobulin level is typically elevated in multiple myeloma, the majority of the antibodies are ineffective monoclonal antibodies from the clonal plasma cell. A selected group of patients with documented hypogammaglobulinemia may benefit from replacement immunoglobulin therapy to reduce the risk of infection.[13]
Neurological symptoms
Some problems (e.g., weakness, confusion, and fatigue) may be due to anemia or hypercalcemia. Headache, visual changes and retinopathy may be the result of hyperviscosity of the blood depending on the properties of the paraprotein. Finally, radicular pain, loss of bowel or bladder control (due to involvement of spinal cord leading to cord compression) or carpal tunnel syndrome, and other neuropathies (due to infiltration of peripheral nerves by amyloid) may occur. It may give rise to paraplegia in late-presenting cases.
When the disease is well-controlled, neurological symptoms may result from current treatments, some of which may cause peripheral neuropathy, manifesting itself as numbness or pain in the hands, feet, and lower legs.
Risk factors
- Monoclonal gammopathy of undetermined significance (MGUS) increases the risk of developing multiple myeloma. MGUS transforms to multiple myeloma at the rate of 1% to 2% per year, and almost all cases of multiple myeloma are preceded by MGUS.[14]
- Obesity is related to multiple myeloma with each increase of body mass index by 5 increasing the risk by 11%.[15]
A familial predisposition to myeloma exists.[16] Hyperphosphorylation of a number of proteins - the paratarg proteins - a tendency which is inherited in an autosomal dominant manner appears a common mechanism in these families. This tendency is more common in African American patients with myeloma and may contribute to the higher rates of myeloma in this group.[16]
Diagnosis
Investigations

The presence of unexplained anemia, kidney dysfunction, a high erythrocyte sedimentation rate (ESR), lytic bone lesions, elevated beta-2 microglobulin, and/or a high serum protein (especially raised globulins or immunoglobulin) may prompt further testing. The globulin level may be normal in established disease. A doctor will request protein electrophoresis of the blood and urine, which might show the presence of a paraprotein (monoclonal protein, or M protein) band, with or without reduction of the other (normal) immunoglobulins (known as immune paresis). One type of paraprotein is the Bence Jones protein which is a urinary paraprotein composed of free light chains (see below). Quantitative measurements of the paraprotein are necessary to establish a diagnosis and to monitor the disease. The paraprotein is an abnormal immunoglobulin produced by the tumor clone.
In theory, multiple myeloma can produce all classes of immunoglobulin, but IgG paraproteins are most common, followed by IgA and IgM. IgD and IgE myeloma are very rare. In addition, light and or heavy chains (the building blocks of antibodies) may be secreted in isolation: κ- or λ-light chains or any of the five types of heavy chains (α-, γ-, δ-, ε- or μ-heavy chains). Patients without evidence of a monoclonal protein may have "nonsecretory" myeloma (not producing immunoglobulins); this represents approximately 3% of all multiple myeloma patients.[17]
Additional findings may include: a raised calcium (when osteoclasts are breaking down bone, releasing calcium into the bloodstream), raised serum creatinine due to reduced kidney function, which is mainly due to casts of paraprotein deposition in the kidney, although the cast may also contain complete immunoglobulins, Tamm-Horsfall protein and albumin.[18]
-
_HE_stain.jpg)
Bone marrow aspirate showing the histologic correlate of multiple myeloma under the microscope. H&E stain.
-

Plasmacytoma. H&E stain.
-

Micrograph showing myeloma cast nephropathy in a kidney biopsy. Hyaline casts are PAS positive (dark pink/red - right of image). Myelomatous casts are PAS negative (pale pink - left of image). PAS stain.
-

Atypical plasma cell infiltrate with both Russell (cytoplasmic) and Dutcher (nuclear) bodies (H&E, 50x).
Work-up


The work-up of suspected multiple myeloma includes a skeletal survey. This is a series of X-rays of the skull, axial skeleton and proximal long bones. Myeloma activity sometimes appear as "lytic lesions" (with local disappearance of normal bone due to resorption), and on the skull X-ray as "punched-out lesions" (pepper pot skull). Magnetic resonance imaging (MRI) is more sensitive than simple X-ray in the detection of lytic lesions, and may supersede skeletal survey, especially when vertebral disease is suspected. Occasionally a CT scan is performed to measure the size of soft tissue plasmacytomas. Bone scans are typically not of any additional value in the workup of myeloma patients (no new bone formation; lytic lesions not well visualized on bone scan).
A bone marrow biopsy is usually performed to estimate the percentage of bone marrow occupied by plasma cells. This percentage is used in the diagnostic criteria for myeloma. Immunohistochemistry (staining particular cell types using antibodies against surface proteins) can detect plasma cells which express immunoglobulin in the cytoplasm and occasionally on the cell surface; myeloma cells are typically CD56, CD38, CD138, CD319 positive and CD19 and CD45 negative.[10] Cytogenetics may also be performed in myeloma for prognostic purposes, including a myeloma-specific FISH and Virtual Karyotype.
Historically, the CD138 has been used to isolate myeloma cells for diagnostic purposes. However, this antigen disappears rapidly ex vivo. Recently, however, it was discovered that the surface antigen CD319 (SLAMF7) is considerably more stable and allows robust isolation of malignant plasma cells from delayed or even cryopreserved samples.[19]
Other useful laboratory tests include quantitative measurement of IgA, IgG, IgM (immunoglobulins) to look for immune paresis, and beta-2 microglobulin which provides prognostic information. On peripheral blood smear the rouleaux formation of red blood cells is commonly seen, though this is not specific.
The recent introduction of a commercial immunoassay for measurement of free light chains potentially offers an improvement in monitoring disease progression and response to treatment, particularly where the paraprotein is difficult to measure accurately by electrophoresis (for example in light chain myeloma, or where the paraprotein level is very low). Initial research also suggests that measurement of free light chains may also be used, in conjunction with other markers, for assessment of the risk of progression from monoclonal gammopathy of undetermined significance (MGUS) to multiple myeloma.
This assay, the serum free light chain assay, has recently been recommended by the International Myeloma Working Group for the screening, diagnosis, prognosis, and monitoring of plasma cell dyscrasias.
The prognosis of myeloma varies widely depending upon various risk factors. The Mayo Clinic has developed a risk-stratification model termed Mayo Stratification for Myeloma and Risk-adapted Therapy (mSMART) which divides patients into high-risk and standard-risk categories. Patients with deletion of chromosome 13 or hypodiploidy by conventional cytogenetics, t(4;14), t(14;16) or 17p- by molecular genetic studies, or with a high plasma cell labeling index (3% or more) are considered to have high-risk myeloma .
Diagnostic criteria
In 2003, the International Myeloma Working Group[10] agreed on diagnostic criteria for symptomatic myeloma, asymptomatic myeloma and MGUS, which was subsequently updated in 2009:[20]
- Symptomatic myeloma (all three criteria must be met):
- Clonal plasma cells >10% on bone marrow biopsy or (in any quantity) in a biopsy from other tissues (plasmacytoma)
- A monoclonal protein (Myeloma protein) in either serum or urine (except in cases of true non-secretory myeloma)
- Evidence of end-organ damage felt related to the plasma cell disorder (related organ or tissue impairment, commonly referred to by the acronym "CRAB"):
- HyperCalcemia (corrected calcium >2.75 mmol/l, >11 mg/dL)
- Renal insufficiency attributable to myeloma
- Anemia (hemoglobin <10 g/dl)
- Bone lesions (lytic lesions or osteoporosis with compression fractures)
Note: Recurrent infections alone in a patient who has none of the CRAB features is not sufficient to make the diagnosis of myeloma. Patients who lack CRAB features but have evidence of amyloidosis should be considered as amyloidosis and not myeloma. CRAB-like abnormalities are common with numerous diseases, and it is imperative that these abnormalities are felt to be directly attributable to the related plasma cell disorder and every attempt made to rule out other underlying causes of anemia, kidney failure, etc.
- Asymptomatic/smouldering myeloma:
- Serum M protein >30 g/l (3 g/dL) and/or
- Clonal plasma cells >10% on bone marrow biopsy and
- No myeloma-related organ or tissue impairment
- Monoclonal gammopathy of undetermined significance (MGUS):
- Serum paraprotein <30 g/l (3 g/dL) and
- Clonal plasma cells <10% on bone marrow biopsy and
- No myeloma-related organ or tissue impairment or a related B-cell lymphoproliferative disorder
Related conditions include solitary plasmacytoma (a single tumor of plasma cells, typically treated with irradiation), plasma cell dyscrasia (where only the antibodies produce symptoms, e.g., AL amyloidosis), and peripheral neuropathy, organomegaly, endocrinopathy, monoclonal plasma cell disorder, and skin changes.
Staging
- International Staging System
The International Staging System (ISS) for myeloma was published by the International Myeloma Working Group in 2005:[21]
- Stage I: β2 microglobulin (β2M) < 3.5 mg/L, albumin ≥ 3.5 g/dL
- Stage II: β2M > 3.5 mg/L and albumin < 3.5 g/dL; or β2M 3.5–5.5 mg/L irrespective of the serum albumin
- Stage III: β2M ≥ 5.5 mg/L
Note that the ISS should be used only in patients who meet diagnostic criteria for myeloma. Patients with MGUS and asymptomatic myeloma who have kidney dysfunction from unrelated causes such as diabetes or hypertension may have elevated β2M levels from the kidney dysfunction and cannot be considered as stage III myeloma. This is one of the limitations of the ISS. It does not really quantify tumor burden or extent unlike staging systems used in other cancers. It is more of a prognostic index rather than a true staging system. For this reason, it is recommended that the ISS be used along with the Durie-Salmon Staging System (see below).
- Durie-Salmon staging system
First published in 1975, the Durie-Salmon staging system[22] is still in use. However, one of the limitations of the Durie-Salmon staging system is the subjectivity in determining the extent of bone disease.
- stage I: all of
- Hb > 10g/dL
- normal calcium
- Skeletal survey: normal or single plasmacytoma or osteoporosis
- Serum paraprotein level < 5 g/dL if IgG, < 3 g/dL if IgA
- Urinary light chain excretion < 4 g/24h
- stage II: fulfilling the criteria of neither I nor III
- stage III: one or more of
- Hb < 8.5g/dL
- high calcium > 12 mg/dL
- Skeletal survey: Three or more lytic bone lesions
- Serum paraprotein > 7g/dL if IgG, > 5 g/dL if IgA
- Urinary light chain excretion > 12g/24h
Stages I, II, and III of the Durie-Salmon staging system can be divided into A or B depending on serum creatinine:
- A: serum creatinine < 2 mg/dL (< 177 μmol/L)
- B: serum creatinine > 2 mg/dL (> 177 μmol/L)
Cellular morphology
The Plasma cells seen in multiple myeloma have several possible morphologies. Typical of plasma cells, they will usually have an eccentric nuclei. Because they are actively producing antibodies, the Golgi apparatus will typically produce a light-colored area adjacent to the nucleus, called a perinuclear halo. The cells may otherwise have the appearance of a normal plasma cell with a single nucleus and a single nucleoli with vesicular nuclear chromatin. Other common morphologies that are seen include:
- Bizarre cells, which are multi nucleated.
- Mott cells, containing multiple clustered cytoplasmic droplets or other inclusions (sometimes confused with auer rods, commonly seen in myeloid blasts)
- Flame cells, having a fiery red cytoplasm.[23] [24]
Pathophysiology
B lymphocytes start in the bone marrow and move to the lymph nodes. As they progress, they mature and display different proteins on their cell surface. When they are activated to secrete antibodies, they are known as plasma cells.
Multiple myeloma develops in B lymphocytes after they have left the part of the lymph node known as the germinal center. The normal cell line most closely associated with MM cells is generally taken to be either an activated memory B cell or the precursor to plasma cells, the plasmablast.[25]
The immune system keeps the proliferation of B cells and the secretion of antibodies under tight control. When chromosomes and genes are damaged, often through rearrangement, this control is lost. Often, a promoter gene moves (or translocates) to a chromosome where it stimulates an antibody gene to overproduction.
A chromosomal translocation between the immunoglobulin heavy chain gene (on chromosome 14, locus q32) and an oncogene (often 11q13, 4p16.3, 6p21, 16q23 and 20q11[26]) is frequently observed in patients with multiple myeloma. This mutation results in dysregulation of the oncogene which is thought to be an important initiating event in the pathogenesis of myeloma. The result is proliferation of a plasma cell clone and genomic instability that leads to further mutations and translocations. The chromosome 14 abnormality is observed in about 50% of all cases of myeloma. Deletion of (parts of) chromosome 13 is also observed in about 50% of cases.
Production of cytokines[27] (especially IL-6) by the plasma cells causes much of their localised damage, such as osteoporosis, and creates a microenvironment in which the malignant cells thrive. Angiogenesis (the attraction of new blood vessels) is increased.
The produced antibodies are deposited in various organs, leading to kidney failure, polyneuropathy and various other myeloma-associated symptoms.
Epigenetic
In a study that investigated the DNA methylation profile of multiple myeloma cells and normal plasma cells, a gradual demethylation from stem cells to plasma cells was observed. The observed methylation pattern of CpG within intronic regions with enhancer-related chromatin marks in multiple myeloma is similar to undifferentiated precursor and stem cells. These results may represent a de novo epigenetic reprogramming in multiple myeloma, leading to the acquisition of a methylation pattern related to stemness.[28]
Prevention
The risk of multiple myeloma can be reduced by maintaining a normal body weight.[29]
Treatment
Treatment for multiple myeloma is focused on therapies that decrease the clonal plasma cell population and consequently decrease the signs and symptoms of disease. If the disease is completely asymptomatic (i.e. there is a paraprotein and an abnormal bone marrow population but no end-organ damage), as in asymptomatic ("smoldering") myeloma, treatment is typically deferred, or restricted to clinical trials.[30]
In addition to direct treatment of the plasma cell proliferation, bisphosphonates (e.g., pamidronate or zoledronic acid) are routinely administered to prevent fractures; they have also been observed to have direct anti-tumor effect even in patients without known skeletal disease. If needed, red blood cell transfusions or erythropoietin can be used for management of anemia. Bortezomib is the first therapeutic proteasome inhibitor approved by the U.S. FDA for treating relapsed multiple myeloma.
Initial therapy
Initial treatment of multiple myeloma depends on the patient’s age and comorbidities. In recent years, high-dose chemotherapy with autologous hematopoietic stem-cell transplantation has become the preferred treatment for patients under the age of 65. Prior to stem-cell transplantation, these patients receive an initial course of induction chemotherapy. The most common induction regimens are bortezomib based regimens, and lenalidomide–dexamethasone.[31] Autologous stem cell transplantation (ASCT), the transplantation of a patient’s own stem cells after chemotherapy, is the most common type of stem cell transplantation for multiple myeloma. It is not curative, but does prolong overall survival and complete remission. Allogeneic stem cell transplantation, the transplantation of a healthy person’s stem cells into the affected patient, has the potential for a cure, but is used in a very small percentage of patients (and in the relapsed setting, not as part of initial treatment).[26] Furthermore, there is a 5–10% treatment-associated mortality rate associated with allogeneic stem cell transplant.
Patients over age 65 and patients with significant concurrent illness often cannot tolerate stem cell transplantation. For these patients, the standard of care has been chemotherapy with melphalan and prednisone. Recent studies among this population[32] suggest improved outcomes with new chemotherapy regimens, e.g., with bortezomib.[33] Treatment with bortezomib, melphalan, and prednisone had an estimated overall survival of 83% at 30 months, lenalidomide plus low-dose dexamethasone an 82% survival at 2 years and melphalan, prednisone and lenalidomide had a 90% survival at 2 years. Head-to-head studies comparing these regimens have not been performed As of 2008.[34]
A 2009 review noted "Deep venous thrombosis and pulmonary embolism are the major side effects of thalidomide and lenalidomide. Lenalidomide causes more myelosuppression, and thalidomide causes more sedation. Chemotherapy-induced peripheral neuropathy and thrombocytopenia are major side effects of bortezomib."[35]
Treatment of related hyperviscosity syndrome may be required to prevent neurologic symptoms or kidney failure.[36][37]
Maintenance therapy
Sometimes after the initial treatment an ongoing maintenance therapy is offered. A 2009 review of maintenance therapy concluded "In younger patients, post-ASCT maintenance therapy with thalidomide appears to increase tumor burden reduction further, which translates in[to] prolonged PFS (Progression-free survival)."[38]
In 2009 maintenance therapy with thalidomide, lenalidomide, or bortezomib was still of questionable benefit.[39]
Relapse
The natural history of myeloma is of relapse following treatment. This may be attributed to tumour heterogeneity. Depending on the patient's condition, the prior treatment modalities used and the duration of remission, options for relapsed disease include re-treatment with the original agent, use of other agents (such as melphalan, cyclophosphamide, thalidomide or dexamethasone, alone or in combination), and a second autologous stem cell transplant.
Later in the course of the disease, "treatment resistance" occurs. This may be a reversible effect,[26] and some new treatment modalities may re-sensitize the tumor to standard therapy. For patients with relapsed disease, bortezomib is a recent addition to the therapeutic arsenal, especially as second line therapy, since 2005. Bortezomib is a proteasome inhibitor. Also, lenalidomide (Revlimid), a less toxic thalidomide analog, is showing promise for treating myeloma. The newly approved thalidomide derivative pomalidomide (Pomalyst in the U.S.) may be used for relapsed and refractory multiple myeloma.
In the 21st century, more patients have survived longer, as a result of stem cell transplant (with their own or a donor's) and treatments combining bortezomib (Velcade), dexamethasone and melphalan or cyclophosphamide. This seems to maintain the monoclonal peak at a reasonable level. Survival expectancy has risen. New treatments are under development.
Kidney failure in multiple myeloma can be acute (reversible) or chronic (irreversible). Acute kidney failure typically resolves when the calcium and paraprotein levels are brought under control. Treatment of chronic kidney failure is dependent on the type of kidney failure and may involve dialysis.
Several newer options are approved for the management of advanced disease:
- ixazomib — an orally available proteasome inhibitor indicated in combination with lenalidomide and dexamethasone in people who have received at least one prior therapy;[40]
- panobinostat — an orally available histone deacetylase inhibitor used in combination with bortezomib and dexamethazone in people who have received at least 2 prior chemotherapy regimens, including bortezomib and an immunomodulatory agent[41] (such as lenalidomide or pomalidomide);
- carfilzomib — a proteasome inhibitor that is indicated:
- as a single agent for the treatment of patients with relapsed or refractory multiple myeloma who have received one or more lines of therapy;
- in combination with dexamethasone or with lenalidomide+dexamethasone for the treatment of patients with relapsed or refractory multiple myeloma who have received one to three lines of therapy;[42]
- elotuzumab — an immunostimulatory humanized monoclonal antibody against SLAMF7 (also known as CD319). It is FDA-approved for the treatment of patients who have received one to three prior therapies (in combination with lenalidomide and dexamethasone);[43]
- daratumumab — a monoclonal antibody against CD38 indicated for the treatment of patients with multiple myeloma who have received at least three prior lines of therapy including a proteasome inhibitor and an immunomodulatory agent or who are double-refractory to a proteasome inhibitor and an immunomodulatory agent.[44]
Palliative care
Multiple national cancer treatment guidelines recommend early palliative care for people with advanced multiple myeloma at the time of diagnosis as well as for anyone who has significant symptoms.[45][46]
Palliative care is appropriate at any stage of multiple myeloma and can be provided alongside curative treatment. In addition to addressing symptoms of cancer, palliative care helps manage unwanted side-effects, such as pain and nausea related to treatments.[47][48]
Prognosis
With high-dose therapy followed by autologous stem cell transplantation, the median survival has been estimated in 2003 to be approximately 4.5 years, compared to a median of approximately 3.5 years with "standard" therapy.[49] Overall the 5-year survival rate is around 35%.[50]
The International Staging System can help to predict survival, with a median survival (in 2005) of 62 months for stage 1 disease, 45 months for stage 2 disease, and 29 months for stage 3 disease.[21]
The prognoses for patients with multiple myeloma, as those with other diseases, are not the same for everyone. The average age of onset is 70 years. Older patients often are experiencing other serious diseases, which affect survival. Younger patients might have much longer survival rates.
Genetic testing
Some myeloma centers now employ genetic testing, which they call a “gene array.” By examining DNA, oncologists can determine if patients are high risk or low risk of the cancer returning quickly following treatment.
Cytogenetic analysis of myeloma cells may be of prognostic value, with deletion of chromosome 13, non-hyperdiploidy and the balanced translocations t(4;14) and t(14;16) conferring a poorer prognosis. The 11q13 and 6p21 cytogenetic abnormalities are associated with a better prognosis.
Prognostic markers such as these are always generated by retrospective analyses, and it is likely that new treatment developments will improve the outlook for those with traditionally "poor-risk" disease.
SNP array karyotyping can detect copy number alterations of prognostic significance that may be missed by a targeted FISH panel.[51] In MM, lack of a proliferative clone makes conventional cytogenetics informative in only ~30% of cases.
- Virtual karyotyping identified chromosomal abnormalities in 98% of MM cases
- del(12p13.31) is an independent adverse marker
- amp(5q31.1) is a favorable marker
- The prognostic impact of amp(5q31.1) over-rides that of hyperdiploidy and also identifies patients who greatly benefit from high-dose therapy.
Array-based karyotyping cannot detect balanced translocations, such as t(4;14) seen in ~15% of MM. Therefore, FISH for this translocation should also be performed if using SNP arrays to detect genome-wide copy number alterations of prognostic significance in MM.
Epidemiology

Multiple myeloma, globally, resulted in about 79,000 deaths in 2013 up from 49,000 in 1990.[7]
United States
In the United States in 2016, there will be an estimated 30,330 new cases and 12,650 deaths.[8] These numbers are based on assumptions made using data from 2011, which estimated the prevalence as 83,367 people, the incidence as 6.1 per 100,000 people per year, and the mortality as 3.4 per 100,000 people per year.
Multiple myeloma is the second most prevalent blood cancer (10%) after non-Hodgkin's lymphoma.[53] It represents approximately 1.8% of all new cancers and 2,1% of all cancer deaths.[8]
Multiple myeloma affects slightly more men than women. African Americans and Native Pacific Islanders have the highest reported incidence of this disease in the United States and Asians the lowest. Results of a recent study found the incidence of myeloma to be 9.5 cases per 100,000 African Americans and 4.1 cases per 100,000 Caucasian Americans. Among African Americans, myeloma is one of the top 10 leading causes of cancer death.
UK
Myeloma is the 17th most common cancer in the UK (around 4,800 people were diagnosed with the disease in 2011), and it is the 16th most common cause of cancer death (around 2,700 people died of it in 2012).[54]
History
The alternative name Kahler's disease is after Otto Kahler.
Other animals
Multiple myeloma affects many other species. The disease has been diagnosed in dogs,[55] cats, and horses.[56]
In dogs, multiple myeloma accounts for around 8% of all haemopoietic tumors. Multiple myeloma occurs in older dogs, and is not particularly associated with either males or females. No breeds appear overrepresented in case reviews that have been conducted.[57] Diagnosis in dogs is usually delayed due to the initial non specificity and range of clinical signs possible. Diagnosis usually involves bone marrow studies, X-rays, and plasma protein studies. In dogs, protein studies usually reveal the monoclonal gammaglobulin elevation to be IgA or IgG in equal incidence.[57] In rare cases the globulin elevation is IgM, which is referred to as Waldenström's macroglobulinemia.[58] The prognosis for initial control and return to good quality of life in dogs is good. 43% of dogs started on a combination chemotherapeutic protocol achieved complete remission. Long-term survival is normal, with a median of 540 days reported.[57] The disease eventually recurs, becoming resistant to available therapies. The complications of kidney failure, sepsis, or pain can lead to an animal's death, frequently by euthanasia.
See also
References
- 1 2 3 4 Raab MS, Podar K, Breitkreutz I, Richardson PG, Anderson KC (July 2009). "Multiple myeloma". Lancet. 374 (9686): 324–39. doi:10.1016/S0140-6736(09)60221-X. PMID 19541364.
- 1 2 "Plasma Cell Neoplasms (Including Multiple Myeloma)—Patient Version". NCI. Retrieved 8 August 2016.
- 1 2 3 4 5 "Plasma Cell Neoplasms (Including Multiple Myeloma) Treatment (PDQ®)–Health Professional Version". NCI. July 29, 2016. Retrieved 8 August 2016.
- ↑ World Cancer Report 2014. World Health Organization. 2014. pp. Chapter 5.13. ISBN 9283204298.
- ↑ World Cancer Report 2014. World Health Organization. 2014. pp. Chapter 2.3 and 2.6. ISBN 9283204298.
- ↑ Global Burden of Disease Study 2013, Collaborators (22 August 2015). "Global, regional, and national incidence, prevalence, and years lived with disability for 301 acute and chronic diseases and injuries in 188 countries, 1990-2013: a systematic analysis for the Global Burden of Disease Study 2013.". Lancet (London, England). 386 (9995): 743–800. PMID 26063472.
- 1 2 GBD 2013 Mortality and Causes of Death, Collaborators (10 January 2015). "Global, regional, and national age-sex specific all-cause and cause-specific mortality for 240 causes of death, 1990-2013: a systematic analysis for the Global Burden of Disease Study 2013.". Lancet (London, England). 385 (9963): 117–71. PMID 25530442.
- 1 2 3 4 "SEER Stat Fact Sheets: Myeloma". NCI Surveillance, Epidemiology, and End Results Program. Retrieved 8 August 2016.
- ↑ Diepenbrock, Nancy H. (2011). Quick Reference to Critical Care. Lippincott Williams & Wilkins. p. 292. ISBN 9781608314645.
- 1 2 3 International Myeloma Working Group (2003). "Criteria for the classification of monoclonal gammopathies, multiple myeloma and related disorders: a report of the International Myeloma Working Group". Br. J. Haematol. 121 (5): 749–57. doi:10.1046/j.1365-2141.2003.04355.x. PMID 12780789.
- ↑ Longo, Dan (2012). Harrison's Principles of Internal Medicine 18th Edition. Mc Graw Hill Medical. p. 938. ISBN 978-0-07-174889-6.
- ↑ Chapel HM, Lee M (1994). "The use of intravenous immune globulin in multiple myeloma". Clin. Exp. Immunol. 97 (Suppl 1): 21–4. PMC 1550368
. PMID 8033429. - ↑ Hargreaves RM, Lea JR, Griffiths H, et al. (1995). "Immunological factors and risk of infection in plateau phase myeloma (stable phase)" (PDF). J. Clin. Pathol. 48 (3): 260–6. doi:10.1136/jcp.48.3.260. PMC 502468
. PMID 7730490. - ↑ Landgren O, Kyle RA, Pfeiffer RM, Katzmann JA, Caporaso NE, Hayes RB, Dispenzieri A, Kumar S, Clark RJ, Baris D, Hoover R, Rajkumar SV (28 May 2009). "Monoclonal gammopathy of undetermined significance (MGUS) consistently precedes multiple myeloma: a prospective study". Blood. 113 (22): 5412–7. doi:10.1182/blood-2008-12-194241. PMC 2689042
. PMID 19179464. - ↑ Roberts, DL; Dive, C; Renehan, AG (2010). "Biological mechanisms linking obesity and cancer risk: new perspectives.". Annual Review of Medicine. 61: 301–16. doi:10.1146/annurev.med.080708.082713. PMID 19824817.
- 1 2 Koura DT, Langston AA (August 2013). "Inherited predisposition to multiple myeloma". Ther Adv Hematol. 4 (4): 291–7. doi:10.1177/2040620713485375. PMID 23926460.
- ↑ Lonial, Sagar, and Jonathan L. Kaufman. "Non-secretory myeloma: a clinician's guide." Oncology (Williston Park, NY) 27.9 (2013): 924-8.
- ↑ Mitchell, Richard Sheppard; Kumar, Vinay; Abbas, Abul K.; Fausto, Nelson. "Multiple myeloma". Robbins Basic Pathology (8th ed.). Philadelphia: Saunders. p. 455. ISBN 1-4160-2973-7.
- ↑ Frigyesi I (Jan 2014). "Robust isolation of malignant plasma cells in multiple myeloma". Blood. 123 (9): 1336–40. doi:10.1182/blood-2013-09-529800. PMID 24385542.
- ↑ Kyle RA, Rajkumar SV (January 2009). "Criteria for diagnosis, staging, risk stratification and response assessment of multiple myeloma". Leukemia. 23 (1): 3–9. doi:10.1038/leu.2008.291. PMC 2627786
. PMID 18971951. - 1 2 Greipp PR, San Miguel J, Durie BG, et al. (2005). "International staging system for multiple myeloma". J. Clin. Oncol. 23 (15): 3412–20. doi:10.1200/JCO.2005.04.242. PMID 15809451.
- ↑ Durie BG, Salmon SE (1975). "A clinical staging system for multiple myeloma. Correlation of measured myeloma cell mass with presenting clinical features, response to treatment, and survival". Cancer. 36 (3): 842–54. doi:10.1002/1097-0142(197509)36:3<842::AID-CNCR2820360303>3.0.CO;2-U. PMID 1182674.
- ↑ "Robbins & Cotran Pathologic Basis of Disease - 9781455726134 | US Elsevier Health Bookshop". www.us.elsevierhealth.com. Retrieved 2016-10-26.
- ↑ Klatt, Edward C. (2011-09-08). Robbins and Cotran Atlas of Pathology. Elsevier Health Sciences. ISBN 1455726834.
- ↑ Federico Caligaris-Cappio; Manlio Ferrarini (1997). Human B Cell Populations. Chemical Immunology. 67. Switzerland: S. Karger AG. p. 105. ISBN 3-8055-6460-0.
- 1 2 3 Kyle RA, Rajkumar SV (2004). "Multiple myeloma". N. Engl. J. Med. 351 (18): 1860–73. doi:10.1056/NEJMra041875. PMID 15509819.
- ↑ Tricot G (2000). "New insights into role of microenvironment in multiple myeloma.". Lancet. 355 (9200): 248–50. doi:10.1016/S0140-6736(00)00019-2. PMID 10675068.
- ↑ Agirre, Xabier; Castellano, Giancarlo; Pascual, Marien; Heath, Simon; Kulis, Marta; Segura, Victor; Bergmann, Anke; Esteve, Anna; Merkel, Angelika (2015-04-01). "Whole-epigenome analysis in multiple myeloma reveals DNA hypermethylation of B cell-specific enhancers". Genome Research. 25 (4): 478–487. doi:10.1101/gr.180240.114. ISSN 1088-9051. PMC 4381520
. PMID 25644835. - ↑ Lauby-Secretan, B; Scoccianti, C; Loomis, D; Grosse, Y; Bianchini, F; Straif, K; International Agency for Research on Cancer Handbook Working, Group (25 August 2016). "Body Fatness and Cancer - Viewpoint of the IARC Working Group.". The New England journal of medicine. 375 (8): 794–798. PMID 27557308.
- ↑ Korde N, Kristinsson SY, Landgren O (2011). "Monoclonal gammopathy of undetermined significance (MGUS) and smoldering multiple myeloma (SMM): novel biological insights and development of early treatment strategies". Blood (journal). 117 (21): 5573–5581. doi:10.1182/blood-2011-01-270140. PMC 3316455
. PMID 21441462. - ↑ Kyle RA, Rajkumar SV (2008). "Multiple myeloma". Blood. 111 (6): 2962–72. doi:10.1182/blood-2007-10-078022. PMC 2265446
. PMID 18332230. - ↑ San Miguel, J.F.; et al. (2008). "Bortezomib plus Melphalan and Prednisone for Initial Treatment of Multiple Myeloma". N. Engl. J. Med. 359 (9): 906–917. doi:10.1056/NEJMoa0801479. PMID 18753647.
- ↑ Curran M, McKeage K (2009). "Bortezomib: A Review of its Use in Patients with Multiple Myeloma". Drugs. 69 (7): 859–888. doi:10.2165/00003495-200969070-00006. PMID 19441872.
- ↑ Durie, B.G.M. (2008). "Treatment of Myeloma — Are We Making Progress?". N. Engl. J. Med. 359 (9): 964–6. doi:10.1056/NEJMe0805176. PMID 18753654.
- ↑ Abraham J (2009). "Advances in multiple myeloma treatment: lenalidomide and bortezomib" (PDF). Community Oncology. 6 (2): 53–55. doi:10.1016/S1548-5315(11)70208-X.
- ↑ Johnson WJ, Kyle RA, Pineda AA, O'Brien PC, Holley KE (April 1990). "Treatment of renal failure associated with multiple myeloma. Plasmapheresis, hemodialysis, and chemotherapy". Arch. Intern. Med. 150 (4): 863–9. doi:10.1001/archinte.1990.00390160111022. PMID 2183734.
- ↑ Paul M, Walker F, Bear RA (November 1982). "Plasmapheresis therapy in a patient with multiple myeloma". Can Med Assoc J. 127 (10): 956. PMC 1862296
. PMID 7139441. - ↑ Harousseau J.-L. (2009). "Maintenance therapy in multiple myeloma". Hematology Reviews. 1 (2): e12. doi:10.4081/hr.2009.e12.
- ↑ "Managing the side effects of lenalidomide and bortezomib" (PDF). Community Oncology: 58. 2009.
- ↑ "Ninlaro (ixazomib) Capsules, for Oral Use. Full Prescribing Information" (PDF). Millennium Pharmaceuticals, Inc. Retrieved 18 August 2016.
- ↑ "Farydak (panobinostat) Capsules, for Oral Use. Full Prescribing Information" (PDF). Novartis Pharmaceuticals Corporation. East Hanover, New Jersey 07936. Retrieved 18 August 2016.
- ↑ "Kyprolis (carfilzomib) for Injection, for Intravenous Use. Full Prescribing Information" (PDF). Onyx Pharmaceuticals, Inc. Thousand Oaks, CA 91320-1799 U.S.A. Retrieved 20 August 2016.
- ↑ "Empliciti (elotuzumab) for Injection, for Intravenous Use. Full Prescribing Information" (PDF). Bristol-Myers Squibb Company. Princeton, NJ 08543 USA. Retrieved 18 August 2016.
- ↑ "Darzalex (daratumumab) Injection, for Intravenous Use. Full Prescribing Information" (PDF). Janssen Biotech, Inc. Horsham, PA 19044. Retrieved 18 August 2016.
- ↑ The American Society of Clinical Oncology has made this recommendation based on various cancers. See American Society of Clinical Oncology, "Five Things Physicians and Patients Should Question" (PDF), Choosing Wisely: an initiative of the ABIM Foundation, American Society of Clinical Oncology, retrieved August 14, 2012
- ↑ Snowden JA, Ahmedzai S, Ashcroft J, et al. (2010). "Guidelines for Supportive Care in Myeloma" (PDF). British Committee for Standards in Haematology.
- ↑ Higginson IJ, Evans CJ (2010). "What is the evidence that palliative care teams improve outcomes for cancer patients and their families?". Cancer J. 16 (5): 423–35. doi:10.1097/PPO.0b013e3181f684e5. PMID 20890138.
- ↑ Lorenz KA, Lynn J, Dy SM, Shugarman LR, Wilkinson A, Mularski RA, et al. (2008). "Evidence for improving palliative care at the end of life: a systematic review.". Ann Intern Med. 148 (2): 147–59. doi:10.7326/0003-4819-148-2-200801150-00010. PMID 18195339.
- ↑ Child JA, Morgan GJ, Davies FE, et al. (May 2003). "High-dose chemotherapy with hematopoietic stem-cell rescue for multiple myeloma". N. Engl. J. Med. 348 (19): 1875–83. doi:10.1056/NEJMoa022340. PMID 12736280. Lay summary – Medscape.
- ↑ Seiter, K; Shah, D; Chansky, HA; Gellman, H; Grethlein, SJ; Krishnan, K; Rizvi, SS; Schmitz, MA; Talavera, F; Thomas, LM (23 December 2013). Besa, EC, ed. "Multiple Myeloma Treatment & Management". Medscape Reference. WebMD. Retrieved 2 January 2013.
- ↑ Avet-Loiseau H, Li C, Magrangeas F, et al. (September 2009). "Prognostic significance of copy-number alterations in multiple myeloma". J. Clin. Oncol. 27 (27): 4585–90. doi:10.1200/JCO.2008.20.6136. PMC 2754906
. PMID 19687334. - ↑ "WHO Disease and injury country estimates". World Health Organization. 2009. Retrieved Nov 11, 2009.
- ↑ Collins CD (2005). "Problems monitoring response in multiple myeloma". Cancer Imaging. 5 (Spec No A): S119–26. doi:10.1102/1470-7330.2005.0033. PMC 1665317
. PMID 16361127. - ↑ "Myeloma statistics". Cancer Research UK. Retrieved 28 October 2014.
- ↑ Ettinger, Stephen J.; Feldman, Edward C. (1 June 2000). Textbook of Veterinary Internal Medicine: Diseases of the Dog and Cat. 1. W.B. Saunders. pp. 516–9. ISBN 978-0-7216-7257-1.
- ↑ MacAllister C, Qualls C, Tyler R, Root CR (August 1987). "Multiple myeloma in a horse". J. Am. Vet. Med. Assoc. 191 (3): 337–9. PMID 3654300.
- 1 2 3 Matus, R.E.; Leifer, C.E.; MacEwen, E.G.; Hurvitz, A.I. (1986). "Prognostic factors for multiple myeloma in the dog". J Am Vet Med Assoc. 11 (188): 1288–92. PMID 3721983.
- ↑ MacEwan, E.G.; Hurvitz, A.I. (1977). "Diagnosis and Management of Monoclonal Gammopathies". Vet Clin North American Small Animal Practice. 7: 119.